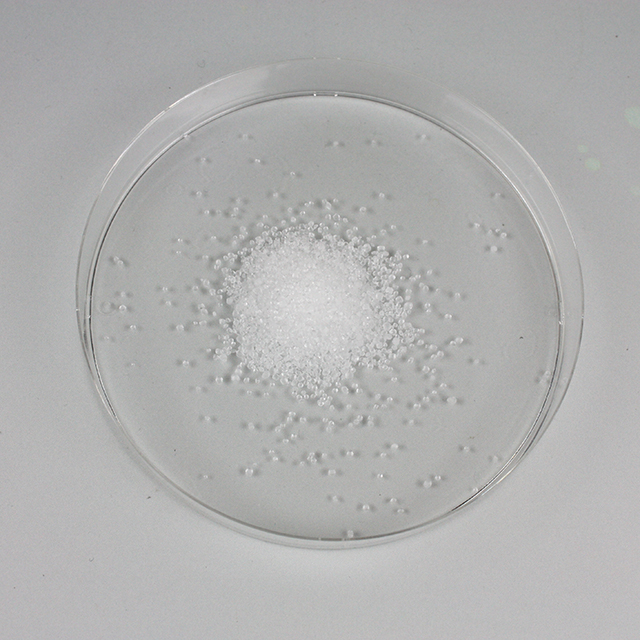

クエン酸「コザカイ・M」
/500g
販売中止
薬価・コード/
製品画像の詳細
| 薬価 | 製品区分・規制区分/リスク分類 | 診療報酬上の後発医薬品 |
|---|---|---|
| 14.20円 / 10g | 医療用医薬品 普通薬 |
| 薬価 | 14.20円 / 10g |
|---|---|
| 製品区分・規制区分/リスク分類 | 医療用医薬品 普通薬 |
| 診療報酬上の後発医薬品 |
| 統一商品コード | 薬価基準収載医薬品コード | 個別医薬品コード(YJコード) |
|---|---|---|
| 288520061 | 7149007X1080 | 7149007X1080 |
| 統一商品コード | 288520061 |
|---|---|
| 薬価基準収載医薬品コード | 7149007X1080 |
| 個別医薬品コード(YJコード) | 7149007X1080 |
| レセプト電算コード | HOTコード | 識別コード |
|---|---|---|
| 610408200 | 1117417300101 | - |
| レセプト電算コード | 610408200 |
|---|---|
| HOTコード | 1117417300101 |
| 識別コード | - |
| 調剤包装単位コード | 販売包装単位コード | 元梱包装単位コード | JANコード |
|---|---|---|---|
(01)04987288520078 |
(01)14987288520068 |
(01)24987288520065 |
4987288520061 |
| 調剤包装単位コード |
(01)04987288520078 |
|---|---|
| 販売包装単位コード |
(01)14987288520068 |
| 元梱包装単位コード |
(01)24987288520065 |
| JANコード |
4987288520061 |
製品情報
クエン酸「コザカイ・M」
Product